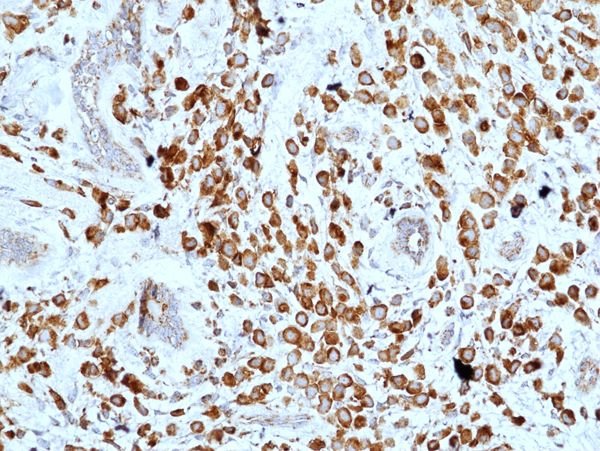

Search
Invitrogen
CD227 (Mucin 1) Recombinant Rabbit Monoclonal Antibody (RM489)
{{$productOrderCtrl.translations['antibody.pdp.commerceCard.promotion.promotions']}}
{{$productOrderCtrl.translations['antibody.pdp.commerceCard.promotion.viewpromo']}}
{{$productOrderCtrl.translations['antibody.pdp.commerceCard.promotion.promocode']}}: {{promo.promoCode}} {{promo.promoTitle}} {{promo.promoDescription}}. {{$productOrderCtrl.translations['antibody.pdp.commerceCard.promotion.learnmore']}}
产品信息
MA562163
种属反应
宿主/亚型
Expression System
分类
类型
克隆号
抗原
偶联物
形式
浓度
纯化类型
保存液
内含物
保存条件
运输条件
RRID
产品详细信息
This antibody reacts to human Muc-1 (Mucin-1).
靶标信息
MUC1 (Mucin 1, Episialin, MAM-6, CA 15-3, PEM and EMA) is a large cell surface mucin glycoprotein expressed by most glandular and ductal epithelial cells and some hematopoietic cell lineages. MUC1 is a transmembrane glycoprotein with a large mucin-like extracellular domain that matures through several intermediate forms generated by proteolysis, and sequential addition and processing of numerous O-linked glycans that are heavily sialylated. MUC1 is highly polymorphic and each allele encodes a product that contains a different number of repeats (between 30 and 90) leading to large differences in molecular weight of the protein. MUC1 is expressed on most secretory epithelium, including mammary gland and some hematopoietic cells, and is expressed abundantly in >90% breast carcinomas and metastases. Transgenic MUC1 has been shown to associate with all four cebB receptors and localize with erbB1 (EGFR) in lactating glands. The MUC1 gene contains seven exons and produces several different alternatively spliced variants. Overexpression, aberrant intracellular localization, and changes in glycosylation of the MUC1 protein have been associated with carcinomas. Multiple alternatively spliced transcript variants that encode different isoforms of the MUC1 gene have been reported, but the full-length nature of only some has been determined. Transgenic MUC-1 has been shown to associate with all four cebB receptors and localize with erbB1 (EGFR) in lactating glands.
仅用于科研。不用于诊断过程。未经明确授权不得转售。
篇参考文献 (0)
生物信息学
蛋白别名: Breast carcinoma-associated antigen DF3; CA 15-3; Cancer antigen 15-3; Carcinoma-associated mucin; CD227; cell membrane protein; DF3 antigen; EMA; Episialin; H23 antigen; H23AG; J19; KL-6; Krebs von den Lungen-6; MUC-1; MUC1; MUC1-alpha; MUC1/E1; transmembrane; devoid of tandem repeats; MUC1/E2; transmembrane; devoid of tandem repeats; longer signal peptide; MUC1/F; transmembrane; MUC1/G; transmembrane; devoid of tandem repeats; MUC1/PC1; MUC1/PC2; MUC1/S1; potential secreted protein; MUC1/S2; potential secreted protein; MUC1/S; potential secreted protein with no tandem repeats; MUC1/SV1; MUC1/SV10; MUC1/SV2; MUC1/SV3; MUC1/SV4; MUC1/SV7; MUC1/SV8; MUC1/SV9; mucin 1, transmembrane; mucin glycoprotein; mucin short variant Y; transmembrane; devoid of tandem repeats; Mucin-1; Peanut-reactive urinary mucin; PEM; PEMT; Polymorphic epithelial mucin; PUM; short variant; tumor associated epithelial mucin; Tumor-associated epithelial membrane antigen; Tumor-associated mucin; Unknown; unnamed protein product
基因别名: ADMCKD; ADMCKD1; ADTKD2; CA 15-3; Ca15-3; CD227; EMA; H23AG; KL-6; MAM6; MCD; MCKD; MCKD1; MUC-1; MUC-1/SEC; MUC-1/X; MUC1; MUC1/ZD; PEM; PEMT; PUM
UniProt ID: (Human) P15941
Entrez Gene ID: (Human) 4582